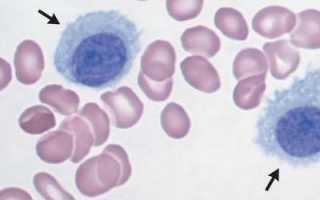

Содержание
Исследование крови назначается пациенту для оценки состояния его здоровья. Довольно часто встречается анизохромия в анализе крови. Это не самостоятельное заболевание, а состояние, которое может свидетельствовать о различных патологиях. У здорового человека анизохромия также присутствует, но в очень маленьком размере.
Что это такое?
Анизохромия — это состояние крови, при котором эритроциты имеют разную окраску. Степень окраски зависит от содержания гемоглобина. Если содержание гемоглобина повышено или понижено, то красные кровяные тельца (эритроциты) окрашиваются неравномерно, то есть могут быть бледнее или ярче нормы.
Эритроциты — это красные кровяные тельца, которые заполняются гемоглобином.

В норме цветовой показатель (ЦП) у здорового человека находится в пределах 0,86-1,04, это определяется термином «нормохромия». При этом эритроциты имеют однородную яркую окраску с небольшим просветлением в середине клетки.
Если ЦП не достигает 0,79, то это называется «гипохромия», эритроциты имеют бледно-розовую окраску, одновременно уменьшается их размер. Превышение показателей также является отклонением от нормы. Если ЦП больше 1,5, то говорят о гиперхромии. В этом случае центральная светлая часть эритроцита будет меньше по размеру или вовсе отсутствовать.
Одновременно наблюдается увеличение толщины клетки.
Анизохромия — это состояние, при котором наблюдается неравномерное распределение цвета в различных участках кожи или слизистых оболочек. Врачи отмечают, что данное явление может быть связано с различными заболеваниями, включая дерматологические и системные расстройства. Например, анизохромия может указывать на наличие воспалительных процессов, инфекций или даже онкологических заболеваний. Специалисты подчеркивают важность своевременной диагностики, так как изменение цвета кожи может быть первым признаком серьезных патологий. Врачам важно учитывать не только визуальные изменения, но и сопутствующие симптомы, чтобы назначить адекватное лечение и предотвратить возможные осложнения.

Причины
Чаще всего причина анизохромии — это различные виды анемии, связанные с нехваткой железа в организме. Также анизохромия присутствует в крови здорового человека, но процент неравномерно окрашенных эритроцитов настолько мал, что не определяется общим анализом.
О наличии у пациента анемии можно говорить, если гипохромия в крови присутствует совместно с другими отклонениями от нормы. Основные причины гипохромии:
- Железодефицитная анемия. Это самая распространенная анемия, характеризующаяся следующими показателями: гипохромия, микроцитоз, низкий уровень сывороточного железа. При лечении препаратами железа показатели приходят в норму.
- Железонасыщенная анемия. При этом концентрация сывороточного железа находится в пределах нормы, но оно плохо всасывается клетками и не достигает тканей. Обычно это состояние развивается из-за длительного приема некоторых лекарственных препаратов или воздействия агрессивных химических веществ (свинца). При этом у больного наблюдается гипохромия, низкий гемоглобин и нормальное содержание железа. Препараты железа никак не влияют на состояние эритроцитов.
- Железоперераспределительная анемия. Развивается в результате разрушения эритроцитов при туберкулезе или воспалительных процессах в сердце (перикардит). У пациента в крови обнаруживается гипохромия, снижение гемоглобина, нормальный уровень сывороточного железа.
Наибольшую опасность представляет собой гиперхромия.

Также причинами гиперхромии могут быть:
- Онкологические опухоли желудка или легких.
- Недостаток фолиевой кислоты.
- Кишечные заболевания.
При обнаружении гиперхромии следует немедленно обратиться к врачу и пройти полное обследование, так как подобное состояние несет непосредственную угрозу здоровью пациента.
Как определяется анизохромия

Количественный показатель эритроцитов считает машина.
А вот цветовой показатель лаборант вычисляет вручную по формуле:
ЦП = (гемоглобин х 3) / первые три цифры содержания эритроцитов.
Важное значение имеет также размер эритроцитов, который определяется либо с помощью автоматической гемолитической системы, либо лаборантом с помощью кривой Прайс Джонса.
Анизохромия — это термин, который вызывает интерес у многих, особенно среди специалистов в области медицины и оптики. Люди обсуждают, как это явление связано с различиями в цвете и прозрачности тканей, что может быть важным для диагностики заболеваний. В медицинских кругах анизохромия часто упоминается в контексте ультразвуковых исследований, где она помогает выявлять патологии. Некоторые пациенты, узнав о таком термине, начинают интересоваться, как это может повлиять на их здоровье. В то же время, в научных сообществах анизохромия рассматривается как важный аспект в изучении свойств материалов и их взаимодействия с светом. Обсуждения на форумах и в социальных сетях показывают, что многие стремятся понять, как анизохромия может быть использована в практических приложениях, от медицины до технологий.

Нормы и отклонения
Для постановки диагноза и определения причины анизохромии оценивается не только цветовой показатель, но и количество эритроцитов, их размер, уровень гемоглобина.
Уровень гемоглобина оценивается следующими цифрами:
- женщины — 120-140 г/л;
- мужчины — 135-160 г/л.
Снижение уровня свидетельствует об анемии:
- 90 г/л — легкая степень;
- 70-85 г/л — средняя;
- менее 65 — тяжелая, когда требуется переливание крови.
ЦП измеряется в единицах и имеет следующие значения:
- 0,86-1 — нормохромия;
- менее 0,82 — гипохромия;
- более 1 — гиперхромия.
При анемии наблюдается изменение размеров эритроцитов.
В медицине приняты следующие показатели:
- 7-8 микрон — нормальные эритроциты (нормоциты);
- более 8 микрон — превышение показателей (макроциты);
- менее 7 микрон — уменьшение показателей (микроциты).
В зависимости от того, какие клетки преобладают, можно говорить о разных видах анемии.
Уменьшение показателей

- Первая. Середина клетки является более светлой по сравнению с нормой.
- Вторая. Красный цвет наблюдается только по периферии эритроцита.
- Третья. Окрашена лишь мембрана клетки, сам эритроцит остается светлым.

Увеличение показателей
В случае гиперхромии эритроциты имеют более насыщенный красный цвет. Различают две степени:
- Первая. Светлая серединка клетки уменьшена в размере.
- Вторая. Светлая серединка клетки отсутствует, эритроцит полностью окрашен в красный цвет.
Обычно гиперхромия сопровождается увеличением размеров клетки (макроцитозом).
Причины снижения железа
Анизохромия развивается из-за нехватки железа в крови. Причинами снижения железа могут быть:
- Кровопотеря вследствие длительных или хронических кровотечений. Такое состояние бывает при травмах, маточном или желудочном кровотечении.
- Обширные воспалительные процессы в желудочно-кишечном тракте, препятствующие всасыванию железа (энтерит, язва), резекция желудка.
- Онкологические опухоли ЖКТ.
- Беременность, подростковый возраст, когда организм нуждается в повышенном количестве железа.
- Плохое питание, связанное с недостаточным употреблением животного белка, например, вегетарианские диеты.
- Хронические болезни, провоцирующие гипоксию (порок сердца, бронхиты).
- Хронические гнойные воспаления (абсцессы, сепсис).
- Длительный прием некоторых лекарств (антибиотиков, гормонов, нестероидных противовоспалительных препаратов).
Причиной развития гиперхромии является гиперхромная анемия.
Она связана с дефицитом витамина В12 и фолиевой кислоты.
- Подобное состояние может быть спровоцировано следующими факторами:
- Нарушением функций костного мозга.
- Воспалительными процессами ЖКТ, мешающими всасыванию витаминов из пищи (колиты, язвы).
- Инфекционными поражениями печени (гепатит).
- Глистной инвазией.
- Беременностью с плохим питание матери.
- Синдромом миелодисплазии, который развивается после применения химиотерапии или лучевой терапии при лечении лейкозов.
Лечение анизохромии предполагает устранение первопричины.
Различные виды анемии лечатся приемом железосодержащих препаратов и витаминно — минеральных комплексов. Если у пациента есть проблемы с желудком, мешающие всасыванию витаминов, то препараты вводятся капельно через вену. При тяжелой степени анемии требуется переливание крови. Также пациенту следует наладить питание, отказаться от соблюдения диеты.
Анизохромия — это довольно частое явление. Важное значение имеет сочетание показателей в анализе крови. На основании этого врач составит четкую картину заболевания и назначит адекватное лечение.
При корректно подобранной терапии прогноз благоприятный.
Вопрос-ответ
Какова причина анизохромии?
Анизохромия – изменение цвета эритроцитов, указывающее на разное содержание гемоглобина в разных эритроцитах. Обычно встречается при тяжёлых формах анемии (заболеваниях костного мозга, гемолитической или токсической анемии, химиотерапии и т. д.).
Что означает повышенный индекс анизоцитоза тромбоцитов?
При превышении показателя можно говорить о развитии у пациента: железодефицитной анемии, гемолитической или мегалобластной анемии при нехватке витаминов группы B, гемоглобинопатии.
Советы
СОВЕТ №1
Изучите основы оптики и цветового восприятия. Понимание того, как свет взаимодействует с различными материалами, поможет вам лучше осознать, что такое анизохромия и как она проявляется в природе и искусстве.
СОВЕТ №2
Обратите внимание на примеры анизохромии в повседневной жизни. Например, наблюдайте за тем, как цвет предметов меняется в зависимости от угла зрения или освещения. Это поможет вам увидеть анизохромию не только в теории, но и на практике.
СОВЕТ №3
Изучите различные материалы, которые демонстрируют анизохромию, такие как некоторые минералы или синтетические полимеры. Это расширит ваши знания о том, как анизохромия используется в науке и промышленности.
СОВЕТ №4
Не забывайте о художественной стороне анизохромии. Попробуйте создать свои собственные художественные работы, используя материалы, обладающие анизохромными свойствами, чтобы увидеть, как цвет может меняться в зависимости от угла и освещения.